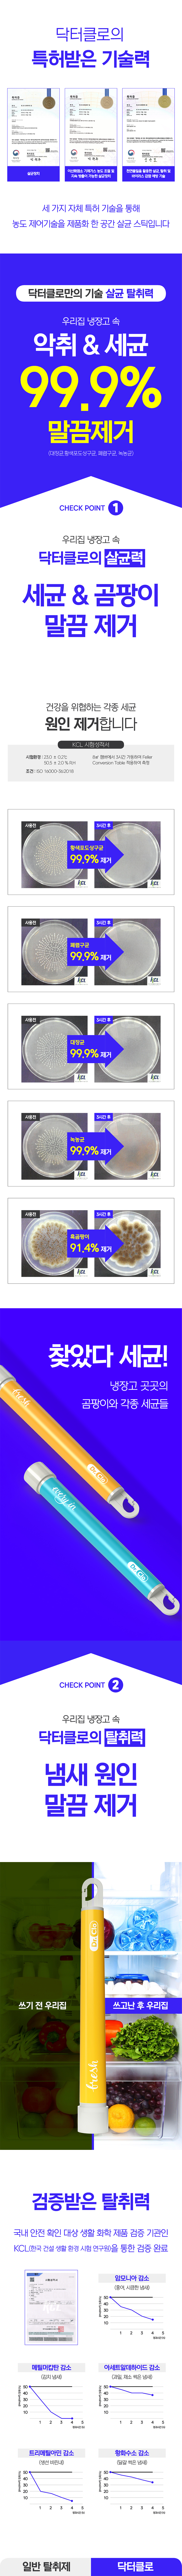
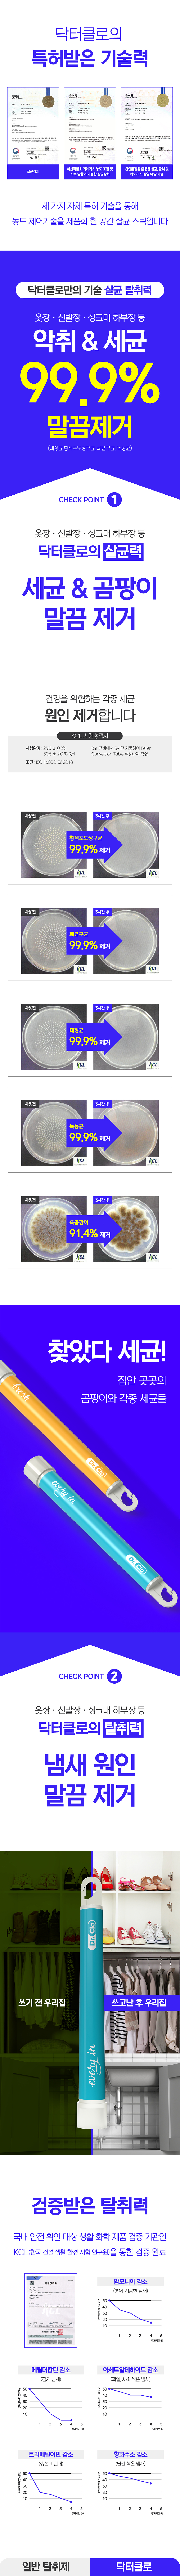

상품이 장바구니에 담겼습니다.
|
|
||
.jpg)
|
|
인기 검색어
|
|
|
|
상세정보 더보기
※ 본 [상품정보고시]는 "상품정보 제공 고시"에 준하여, 의무적으로 표시하는 정보이며,
[상품정보고시]와 [제품상세정보]의 내용이 일치하지 않을 경우에는 [상품정보고시]가 더 정확한 정보입니다.
|
|
배송비는 업체의 기본배송정책과 상품마다 배송정책이 다를수가 있습니다.
상품에 적용된 배송정책은 상품에게만 적용되며 기본 배송정책에는 영향을 받지 않습니다.
|
|
■ 반품비 : 본상품을 고객님의 단순변심으로 교환 혹은 반품할 경우 <왕복 택배비>는 고객님 부담입니다. (->택배비는 상품별, 지역별로 다를 수 있습니다.) ■ 교환 및 반품이가능한 경우 1. 주문 상품 수령 후 사용하지 않으신 경우에 한하여, 상품을 받거나 공급이 개시된 날로부터 7일 이내 교환 및 반품을 신청하실 수 있습니다. 2. 주문 시 안내 받은 상품의 광고 사항과 다른 상품이 배송 된 경우 수령일로부터 3개월 이내, 알 수 있었던 날부터 30일 이내 교환 및 반품이 가능합니다. ■ 교환 및 반품이 불가능한 경우 1. 교환/반품 가능기간이 경과된 경우 2. 고객님의 책임 있는 사유로 상품이 멸실 또는 훼손된 경우 (단, 상품의 내용확인을 위한 포장훼손 등은 제외) 3. 고객님의 사용 또는 일부 소비에 의하여 상품의 가치가 현저히 감소한 경우 (예:화장품, 식품 등) 4. 시간의 경과에 의하여 재판매가 곤란할 정도로 상품가치가 현저히 감소한 경우 (예:계절상품, 식품 등) 5. 포장을 개봉하여 사용하거나 또는 설치가 완료되어 상품의 가치가 훼손된 경우 (예:설치가전/가구 등) 6. 상품 고유의 포장이 훼손되어 상품가치가 상실된 경우 (예:Tag/라벨이 훼손된 수입 명품 등) 7. 복제가 가능한 상품의 포장 등을 훼손한 경우 (예:CD/DVD/GAME/BOOK 등) 8. 고객님의 주문확인 후 상품제작이 들어가는 주문제작상품으로서 청약철회 제한상품 9. 그 외 전자상거래등 에서의 소비자보호에 관한 법률이 정하는 청약철회 제한에 해당하는 경우 |
|
|
|
|
| 판매자명 | 주식화사 가울 | 대표자명 | 남인현 | 이메일 | md@gaulpost.co.kr |
|---|---|---|---|---|---|
| 연락처 | 070-4827-4091 | 팩스 | 영업소재지 | 경기 구리시 산마루로 14 (갈매동) W타워 301호 |
 |
이용약관 | 회사소개 | 이용안내 | 개인정보취급방침 | 제휴문의 | 판매자(입점)신청 | 미네랄이야기 | 가맹점안내 | |  |
 |
|
|
|
||||||||||





 복수구매
복수구매










